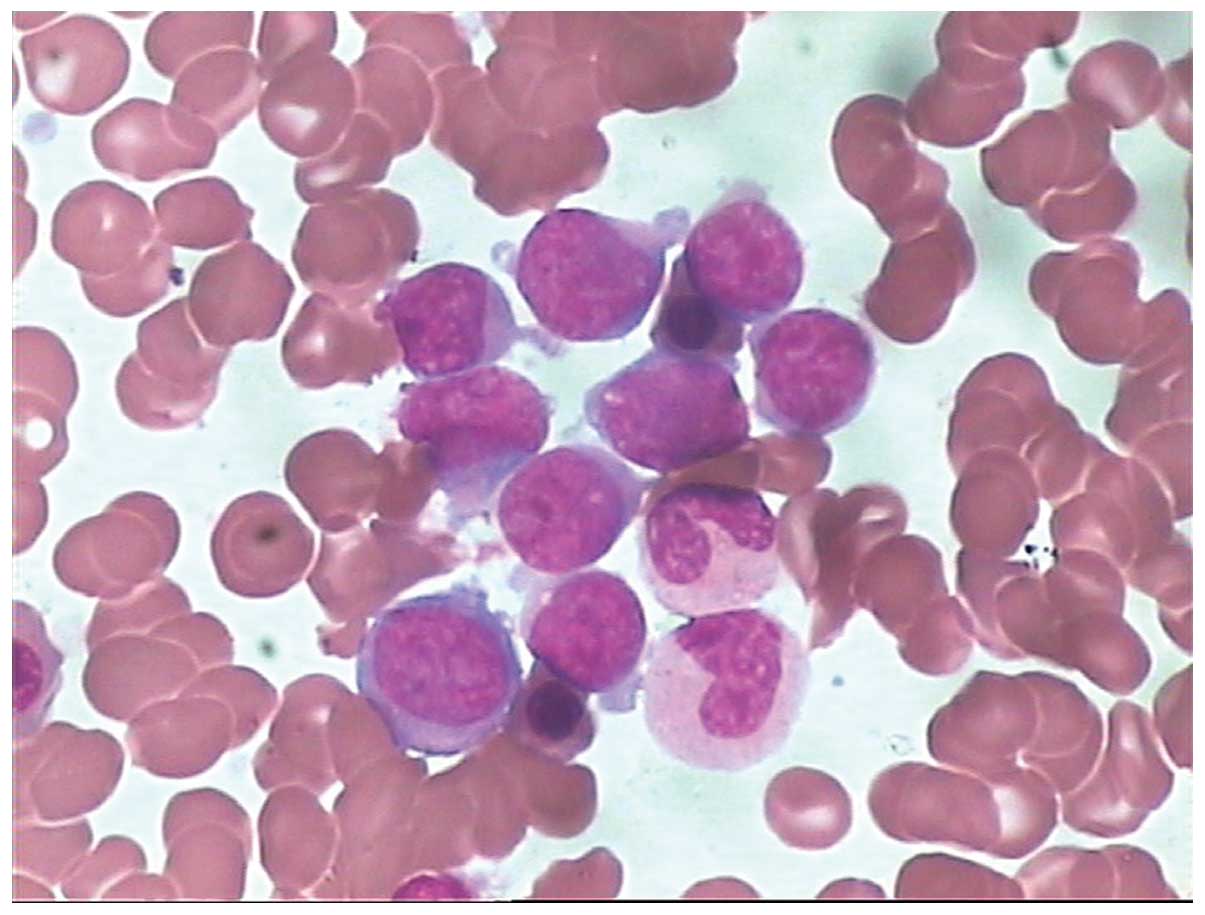

Острая лимфоцитарная лейкемия: Симптомы и лечение

Раздел: Фотоархив познания